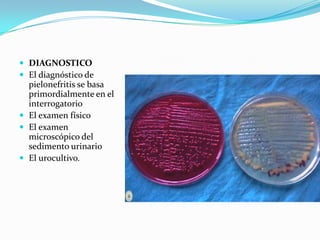
 DIAGNOSTICO
 El diagnóstico de
  pielonefritis se basa
  primordialmente en el
  interrogatorio
 El examen físico
 El examen
  microscópico del
  sedimento urinario
 El urocultivo.

1. Los riñones son órganos encargados de eliminar los residuos nitrogenados a través de la orina. 2. Están formados por la corteza y la médula y contienen las nefronas, que son las unidades funcionales de filtración. 3. La orina pasa de los riñones a la vejiga a través de los uréteres para luego ser expulsada por la uretra.



























![Vejiga urinaria
La vejiga urinaria es un órgano
hueco músculo-membranoso que
forma parte del tracto urinario y que
recibe la orina de los uréteres, la
almacena y la expulsa a través de la
uretra al exterior del cuerpo durante
la micción.
En griego, vejiga se escribe κύστις
[cistos], por lo que todas las
palabras que se refieren a ella
comienzan con cist-, como cistitis,
cistotomía, cistoscopia, etc.](https://image.slidesharecdn.com/aparatourinario-120517000426-phpapp02/85/Aparato-Urinario-28-320.jpg)